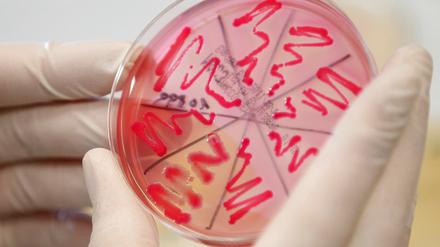
Schwere Darmerkrankungen mit dem gefährlichen EHEC-Erreger breiten sich in Deutschland weiter aus.

Was Kirchen und Verbände bislang nicht erreicht haben, hat Christine Bergmann mit ihrem Bericht geschafft. Nun wird sich zeigen, wie ernst es die Gesellschaft mit den Betroffenen meint.

Was Kirchen und Verbände bislang nicht erreicht haben, hat Christine Bergmann mit ihrem Bericht geschafft. Nun wird sich zeigen, wie ernst es die Gesellschaft mit den Betroffenen meint.
Nach dem Meisterstück folgt der Absturz: Die Fußballer des SV Babelsberg werden in der nächsten Saison entweder in einer unteren Liga spielen – oder gar nicht mehr.
Opfer aus DDR-Heimen kamen bislang zu kurz – nun wird vehement ihre Gleichstellung verlangt Kritik an Kirchen wegen Umgangs mit Kindern.
In kirchlichen Kinderheimen der Nachkriegszeit gab es rigide Erziehungsmethoden.
Die Höhe von Schmerzensgeld und Entschädigungszahlungen hängt nicht nur von der Schwere der Taten ab, sondern auch davon, was in den Ländern üblich ist und was die jeweiligen Opferentschädigungsgesetze vorschreiben. In Irland haben die katholische Kirche und der Staat im Schnitt 60 000 Euro an Betroffene gezahlt, die als Kinder oder Jugendliche in kirchlichen Einrichtungen missbraucht wurden.
Die unabhängige Beauftragte der Bundesregierung, Bergmann, fordert öffentliche Hilfe für Betroffene – Opfergruppen würdigen Arbeit der früheren Ministerin.

Die SPD sieht einer Serie von Siegen auf dem Weg zur Bundestagswahl entgegen, meinen führende Genossen: Hamburg, Bremen, Berlin. Abwegig ist es nicht - wenn die SPD nicht nach jedem Erfolg Pläne auspacken würde, die sagen: Wir glauben selbst nicht daran.

Das August-Bebel-Institut zeigt ab Freitag die Geschichte von 15 Arbeitsmigrantinnen der ersten Generation. Die Bilder und Texte dokumentieren ein Stück deutsche Geschichte, über das viel zu wenig bekannt ist.

Auf dem Festakt zum 20-jährigen Jubiläum der Deutschen Bundesstiftung Umwelt hat Angela Merkel eine "alternative Wohlstandsmessung" gefordert. Zum Atomausstieg wollte sie nichts sagen.
Linksextremisten haben eine Kabelbrücke in Brand gesetzt – mit großen Folgen: für die S-Bahn, für Krankenhäuser und auch für sie selbst. Beifall jedenfalls spendet erstmals niemand.

Die Kampagne „Musik 2020 Berlin“ soll Clubs und Labels endlich eine Lobby geben und bei Politikern um Unterstützung werben.

Nach dem EHEC-Ausbruch arbeiten die Forscher unter Hochdruck. "E.coli O104" soll Ursache der Infektionen sein - ein sehr seltener Erreger. Nun gibt das Robert-Koch-Institut eine erste Warnung heraus.

Die Ohrfeige als kulturelles Phänomen wird mal heillos überschätzt, mal hoffnungslos unterschätzt. In jedem Falle lohnt es sich, öfter mal darüber nachzudenken.

Von Tür zu Tür: Wie Seuchenexperten versuchen, die Quelle der EHEC-Infektion ausfindig zu machen. Einen ersten Hinweis gibt es in Frankfurt am Main.

Bei einem Sprengstoffanschlag in Afghanistan ist ein Bundeswehrsoldat ums Leben gekommen. Einem Medienbericht zufolge gab es einen Anschlag mit einem versteckten Sprengsatz auf eine deutsche Patrouille im Norden Afghanistans.
Zwei Tage nach dem Brandanschlag auf die Berliner S-Bahn gibt es weiterhin Verzögerungen im Linienverkehr. Wo Fahrgäste heute Geduld brauchen.

Frankreichs Finanzministerin Christine Lagarde hat offiziell ihre Kandidatur für die Führung des Internationalen Währungsfonds erklärt. Der bisherige IWF-Chef Strauss-Kahn war nach seiner Festnahme wegen des Vorwurfs der versuchten Vergewaltigung zurückgetreten.
DER PLANSüdlich des Humboldt-Forums rund um den entstehenden Petriplatz soll ein dichtes innerstädtisches Quartier entstehen. Der Senat hat am Dienstag einen Bebauungsplan-Entwurf für den historischen Kern von Alt-Cölln um die Gertraudenstraße und die Breite Straße beschlossen.
Spätestens zum 1. Juni haben üblicherweise alle Hochschulen ihre Online-Portale für Bewerbungen in NC-Fächern freigeschaltet – so auch in Berlin die FU und die TU.
Es kann lebensbedrohlich sein. Das Darmbakterium EHEC breitet sich in Norddeutschland rasant aus. Wie ernst ist die Lage?
Die Regierung hat sich endgültig von den umstrittenen Sperren für kinderpornografische Inhalte im Internet verabschiedet. Das schon ausgesetzte Sperrgesetz soll aufgehoben werden. Künftig sollen die Seiten gelöscht statt gesperrt werden.
Die Welle von schweren Darminfektionen in Norddeutschland hat nun Todesopfer gefordert. Eine 83-jährige Frau im niedersächsischen Landkreis Diepholz ist der Krankheit erlegen. Bei einem weiteren Todesfall ist noch unklar, ob eine EHEC-Infektion Ursache war.
In der Nacht von Dienstag auf Mittwoch haben Unbekannte zwei teure Autos angezündet. Eines war in Prenzlauer Berg, das andere in Mitte geparkt. Ob die Tat politisch motiviert war, ist noch unklar.
Das gegenwärtig als Dorint-Hotel geführte Haus kehrt nach einer Übergangsperiode von nur zwei Monaten am 1. Juni zur Intercontinental-Hotelgruppe (IHG) zurück. Das Re-Branding wird wohl hohe Kosten verursachen.

Der aktuelle EHEC-Ausbruch ist ungewöhnlich und beunruhigend. Bei vielen Erkrankten tritt eine sonst seltene Komplikation auf. Die Quelle der Infektionen ist weiter unklar. Wurden die Bakterien gar absichtlich ausgebracht?
Ich habe als Lagerhilfe gearbeitet, damals war ich 17. Das war bei einer Frankfurter Firma namens Telenorma.

Klinikkonzerne planen am Flughafen BBI ein großes Gesundheitszentrum – für Patienten aus aller Welt. Zwischen 80.000 und 100.000 Patienten sollen dort jährlich versorgt werden.
Lichtenberg ehrt die Nazi-Widerständler der „Roten Kapelle“ mit einem Denkmal. Es besteht aus einer hochragenden Stahlplatte und ist das erste Denkmal für dieses Netzwerk seit der deutschen Einheit.
Die Unwetter im Süden der USA nehmen kein Ende. Während in der schwer verwüsteten Stadt Joplin in Missouri noch immer nach Überlebenden gesucht wird und die Zahl der Opfer weiter steigt, hat ein neuer Tornado in Oklahoma weitere Menschenleben gekostet.

Zwei Tage nach dem Brandanschlag auf die Berliner S-Bahn gibt es weiterhin Verzögerungen im Linienverkehr. Wo Fahrgäste heute Geduld brauchen.
Schon wieder haben Terroristen in Pakistan einen Selbstmordanschlag verübt. Ein mit Sprengstoff beladenes Auto raste in eine Polizeistation. Mindestens zwei Beamte starben.
Massentauglich ab sechs Jahren: Das neue Album "Born This Way" von Lady Gaga ist in erster Linie "Kirmestechno" - und enthält eine lustige Verballhornung des Deutschen.

Berlin bereitet die Sperrung des Luftraumes vor, da die Aschewolke des isländischen Vulkans Grímsvötn nun auch Richtung Deutschland zieht. An den Flughäfen Bremen und Hamburg gibt es bereits Flugverbote.
Historisches Umfeld des Berlines Schlosses lässt sich wegen Auflagen kaum wiederherstellen. Am heutigen Mittwoch stellt Stiftung ihre Baupläne vor
Spendenlauf für Mukoviszidose-Erkrankte
Glaubt man den Größen der großen Potsdamer Sportvereine, die dieser Tage gern hinter den Kulissen versuchen, Journalisten und Redaktionsleitungen von der Notwendigkeit des Potsdamer Systems der ganz eigenen Sportförderung zu überzeugen, dann droht in Potsdam der Weltuntergang. Täter: einige Journalisten.
Originalpass-Beschaffung schwierig / Freispruch
Kristall Bäder AG betreibt nun auch Trimini in Bayern
Stahnsdorf - Die Stahnsdorfer Fluglärmgegner sind erschöpft: „Wir haben in den letzten Monaten nicht nur unseren Feierabend sondern auch einen Teil unseres Urlaubs für den Protest gegen die Flugrouten geopfert“, sagte Dietmar Otto (SPD) bei einem Bürgerforum am Montagabend. Otto sitzt für die Gemeinde in der Fluglärmkommission, die wenige Stunden zuvor getagt hatte.

Am Freitag soll Bahn wieder planmäßig fahren
DER PLANSüdlich des Humboldt-Forums rund um den entstehenden Petriplatz soll ein dichtes innerstädtisches Quartier entstehen. Der Senat hat am Dienstag einen Bebauungsplan-Entwurf für den historischen Kern von Alt-Cölln um die Gertraudenstraße und die Breite Straße beschlossen.

Noch bis Sonntag „Gartenschönheit in Vasen“
Dem SV Babelsberg 03 fehlen anderthalb Millionen Euro – nun droht der Zwangsabstieg
Potsdam - Brandenburger Homosexuelle in eingetragenen Lebenspartnerschaften sollen Ehepaaren künftig in allen auf Landesebene geregelten Rechten gleichgestellt werden. Einem entsprechenden Gesetzentwurf stimmte das Kabinett am Dienstag in Potsdam zu, wie Familienstaatssekretär Wolfgang Schroeder mitteilte.

„Geschichtsunterricht kann ganz schön trocken und langweilig sein“, gibt selbst Jürgen Luh, Historiker der Stiftung Preußische Schlösser und Gärten Berlin-Brandenburg (SPSG), zu. Um seinem Kurs die Epoche Friedrichs des Großen näher zu bringen, ließ Peter Schweinhardt, Lehrer am Babelsberger Filmgymnasium, die Schüler an einem Wettbewerb der SPSG teilnehmen.
Landesgesundheitsministerium informiert im Internet. Fünf mögliche Infektionen in Berlin

Ernährungsforscher kennen heute eine Vielzahl von Faktoren, die das Darmkrebsrisiko senken können
Das Angebot von Therapien und Entschädigung sind eine Möglichkeit, wie die Gesellschaft Opfern sexueller Gewalt helfen kann. Mindestens genauso wichtig ist es, hinzuhören, nachzufragen und mitzufühlen.
öffnet in neuem Tab oder Fenster